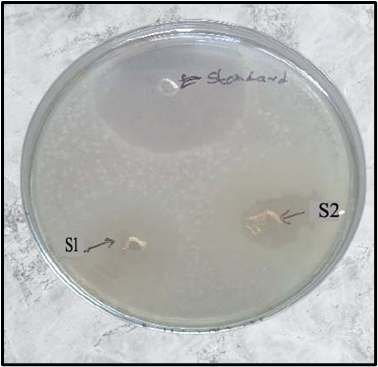

Abstract
In modern times, herbs are employed all over the world because of their potential in medicine and pharmacology. Herbs are also utilized to protect people against several kinds of infections. The alcoholic extract of Milletia pinnata L. also referred to as green karanj was utilized in the current study to create handwash. (natural). Green karanj has been utilized historically and is recognized for its distinct pharmacological activity. Using sodium lauryl sulfoacetate (SLSA) as a surfactant, carbopol-934 as a gelling agent, and TEA (triehanolamine) as a neutralizer, an alcoholic extract of Milletia pinnata L.-loaded herbal hand wash was created. The antibacterial action of herbalism handwash gel was studied by the paper disc approach. Bacillus subtilis, E.coli, and S.aureus are utilized to assess the gel's ability to fend off microbes. It exhibits promising activity against Bacillus subtilis. By examining morphological characteristics such odour, color, pH, foam height, consistency, and retention in accordance with chemical standards, the herbalism handwash gel's physicochemical characterization was carried out. The results of the created herbal hand wash formulation are within the acceptable range and no adverse effects were observed.
Keywords
Milletia Pinnata L., Extraction, Herbalism Handwash, Gel, Antimicrobial Study.
Introduction
One of the body's most vulnerable parts is the skin., it needs to be shielded from harmful microbes like viruses, bacteria, fungi, and others. Keeping your hands clean is crucial for keeping infectious diseases from spreading and shielding the epidermis from harmful microbes. Typically, hands are the main way that diseases and germs are spread. Thus, hand wash is used to maintain hand hygiene. [1]. A well-known medication used primarily for skin-related issues, Karanj (Milletia pinnata Linn.) is referenced in practically all Ayurvedic classical literature. It is described in the Dravya of Astang Hridyam's Aragvadhadi, Varunadi, and Arkadi [2]. Using both contemporary and Ayurvedic standards, we measured the effectiveness of the leaf extract. We prepared from Karanj. The plant M. pinnata has several distinct chemical components. The most often used components for isolation are flavonoids and their derivatives. Flavones are the byproducts of flavonoids. Chalcones and flavans. This plant also contains amino acids, disaccharides, fatty acids, steroids, triterpenes, diterpenes, and ester compounds. The leaves can be used as a antifungal, antibacterial, laxative, anthelmintic, and digestive aid for wounds, piles, and inflammations. Colds, coughs, diarrhea, dyspepsia, flatulence, gonorrhea, and leprosy are all treated with their juice. In desert areas, goats and cattle consume the fresh leaves. [3]

Figure 1: Plant of Karanj
Glycosides, alkaloids, tannins, saponins, terpenoids, and flavonoids are examples of secondary metabolites that are present in plants and are in responsibility for different pharmacological actions. From the literature review indicates that the extract from Milletia pinnata Linn leaves has antibacterial and antimicrobial properties. Therefore, our goal was to create and assess herbal handwash gel utilizing the best excipients for herbal handwash production. [4-5]
MATERIALS AND METHODS:
Extraction of karanj Leaves (Ethenolic extraction)
Developing an ethanolic Karanj extract In Raigarh, Chhattisgarh, India, the leaves of Milletia pinnata Linn, often known as green karanj, Dr. Devendra Choudhary, Department of Plant Breeding, College of Agriculture & Research Station Katghora, Chhattisgarh, India, verified the plant's botanical identity in March–April 2024. Ethanol was used to extract one kilogram of shade-dried powdered leaves using the Soxhlet apparatus. The solvent was extracted from the entire extract to create a concentrate, which was then put on a water bath to turn into a syrup mass and finally dried by evaporation. (33gram) [6]

Figure 2: Dried Powder of Karanj Leaves

Figure 3. Extraction of Milletia pinnata Linn (Karanj)
Qualitative analysis
To examine the various phytoconstituents found in the alcoholic extract of Milletia pinnata Linn, a preliminary phytochemical screening was conducted. The testing for phytoconstituents were conducted, and the outcomes are shown below:
Identification of phytoconstituents by chemical tests
Alkaloid Test
Mayer’s test: One milliliter of the drug's acidic aqueous extract should be mixed with a few drops of Mayer's reagents. It turns white or light yellow.
Wagner’s Test: Add a few drops of Wagner's reagent and 1.5% v/v HCl to 1 milliliter of the alcoholic extract to acidify it.
Carbohydrate Test
Benedict’s test: Add 5 ml of Benedict's solution to 0.5 ml of the drug's aqueous extract, then boil for 5 minutes. Carbohydrates are what cause colored.
Fehling’s test: Add 1 ml of the mixture to 2 ml of the drug's aqueous extract. of equal parts Fehling's solutions A and B, then bring the contents of the test tube to a boil for a short while. A brick-red or red is created.
Resins Test: One milliliter of extract should be dissolved in one milliliter of acetone before being added to five milliliters of distilled water. The presence of resins is indicated by turbidity.
Saponins Test: around 5 milliliters of an aqueous solution in a test tube. Add a few drops of sodium bicarbonate to the medication extract. Give it a good shake, then step away for a few minutes. A structure like a honeycomb form.
Flavonoids Test Add five to ten drops of diluted hydrochloric acid and a tiny piece of "Mg" to the test tube with 0.5 milliliters of the drug's alcoholic extract. When flavonoids are present, a pink, reddish pink, or brown hue is created.
Tannins Test A few drops of 5?Cl3 solutions should be added to 1–2 milliliters of drug extract. Gallacto tannins are indicated by a greenish tint, whereas brown tannins are shown by a brown tint. [7–9]
Preparation of herbal hand-wash
Carbopol-940 was used to produce the herbal handwash gel.as a gel-forming agent (1% w/w con.) for one day. After then, the in-fledged was stirred with a mechanical agitator to ensure that the gel was distributed evenly. Then, while continuously stirring, add small quantities of TEA to bring the pH down to 7.0. The extract of Milletia pinnata Linn leaves was then incorporated into the base to create a herbal handwash formulation. In addition, Rosewater (15 ml) and sodium lauryl sulfoacetate (0.4 g) were absorbed. [10]
Characterization of Prepared Formulation
Antimicrobial Activity
Disc diffusion method: To find out if a zone of inhibition envelops the disks, paper disks soaked in antimicrobial agents are set on a lawn of bacteria that has been sown on the surface of an agar medium. The plate is then incubated for the entire night. Regarding the range of antimicrobial medications that can be tested, this approach is among the most adaptable susceptibility testing techniques. Three separate tests were conducted to evaluate the antibacterial properties of herbal handwash against microorganisms. Typically, ciprofloxacin is utilized. The organisms that are utilized are B. subtilis, S. auroginosa, E. coli, and S. aureus. [11]
Physical-chemical assessment of the formulation
The prepared herbalism hand wash gel's appearance, pH, viscosity, foam height, and retention were the basis for its physico-chemical evaluation.
Appearance and uniformity
A visual examination was used to assess the hand wash gel's morphological or physical characteristics, including color, odour, and texture. [12]
pH
2 grams of herbal handwash were dissolved in 200 ml of distilled water. A digital pH meter that had been previously standardized was used to measure the solution's pH.
Determination of viscosity
Herbal handwash's viscosity was measured using a digital Brookfield viscometer.
Determination of foam height
One gram of herbal gel-based hand wash sample was combined with fifty milliliters of water. After that, it is moved to a 250 ml beaker with a cork. The capacity was raised to 100 mL by using distilled water. After letting the solution stand for 25 movements until the aqueous volume reached 100 ml, the height of the foam above the solution was measured. [13]
Evaluation of gel's ability to retain foam
Ten shakes were performed on a 100 mL measuring cylinder that held 50 mL of herbal gel-based hand cleaner. For five minutes, the volume of foam was monitored every minute. It should take at least five minutes for the foam retention to stabilize. [14]
Grittiness
To test the formulation's grittiness, 1 milliliter of sample was applied to the fingertips and rubbed between two fingertips. [15]
Skin Irritation
The solution was applied to the hand's skin, left on for 30 minutes, and any lingering irritation was assessed. [16]
RESULTS AND DISCUSSION:
Phytochemical Screening:
To screen for phytochemicals, a qualitative analysis of an alcoholic extract of Milletia pinnata leaves was conducted. The outcomes indicate that the alcoholic extract of Milletia pinnata leaves contains alkaloids, glycosides, terpenoids, flavonoids, and saponins. The extract's antimicrobial activity was assessed after it was further prepared in gel dosage form.
Table 1. Phytochemical screening
|
S/N
|
Phytochemical
|
Test
|
Observation
|
Result
|
|
1
|
Alkaloid Assessment
|
Mayers
|
Colour obtained - pale yellow
|
+
|
|
|
|
Wagner’s
|
Yellowish to Brownish ppt. shown
|
+
|
|
2
|
Carbohydrate Assessment
|
Benedict’s
|
coloured ppt shown
|
+
|
|
|
|
Fehling’s
|
reddish or brick red precipitated is formed
|
+
|
|
3
|
Resins Assessment
|
|
Turbidity is formed
|
Resins confirmed
|
|
4
|
Saponins Assessment
|
|
Shown Honey comb – like structure
|
Saponin confirmed
|

Figure 4. Phytochemical Screening
Table 2. Preparation of herbal hand-wash
|
S. No.
|
Ingredients
|
Quantity
|
|
1
|
Alcoholic extract of Milletia Pinnata Linn (Karanj)
|
20 ml
|
|
2
|
Carbopol-940
|
1%w/w
|
|
3
|
Sodium Lauryl Sulfoacetate (SLSA)
|
7 gms
|
|
4
|
Glycerin
|
35 ml
|
|
5
|
Methyl Paraben
|
0.5 ml
|
|
6
|
Lemon oil
|
4 ml
|
|
7
|
Purified Water q. s
|
100 ml
|
Characterization of Herbalism Handwash
Antimicrobial Activity
The herbalism's antibacterial effectiveness the agar plate method was used to evaluate hand wash formulations' ability to inhibit the growth of E. Coli, Bacillus subtilis, and S. aureus. The ethenoholic extract of the plant leaf extract utilized to make the hand wash has potent antibacterial qualities, according to the zone of inhibition test results. The antimicrobial efficacy of the polyherbal handwash was evaluated against common pathogens, including S. aureus, E. coli, and Candida albicans. The results indicated that the polyherbal handwash demonstrated a significant inhibitory effect against all tested pathogens, with a zone of inhibition ranging from 15-18 mm.
Table 3. Zone of Inhibition of formulation
|
S. No.
|
Sample
|
S. aureus
|
B. subtillis
|
E. coli
|
|
1
|
Azithromycin
|
26mm
|
22mm
|
20mm
|
|
2
|
20 mg/ml
|
13mm
|
14mm
|
15mm
|
|
3
|
50mg/ml
|
15mm
|
16mm
|
18mm
|
- Staphylococcus aureus: A strong antimicrobial effect was observed, highlighting the handwash’s ability to combat common skin infections.
- Escherichia coli: The formulation exhibited moderate antibacterial activity, suggesting its potential for use in preventing gastrointestinal infections.
- Candida albicans: The handwash also displayed antifungal activity, which supports its use in preventing fungal skin infections.
These findings suggest that the Milletia pinnata-based polyherbal formulation not only cleanses the skin but also offers additional benefits by protecting against harmful microorganisms, making it a highly effective antimicrobial handwash.

Figure 5. Zone of Inhibition of herbalism handwash gel
pH of the Handwash
The pH of the herbalism handwash formulation was obtained to be 6.8, which falls within the ideal pH range for skin care products (4.5–7.0). A slightly acidic pH ensures that the product is skin-friendly and helps to maintain the skin's natural acid mantle, providing mild cleansing properties without causing irritation or dryness. The formulation containing Milletia pinnata Linn. (Karanj), known for its antimicrobial and anti-inflammatory properties, does not alter the pH significantly, thus confirming its suitability for use in a handwash.
Colour of the Handwash
The color of the polyherbal handwash was observed to be pale green, which can be attributed to the natural phytoconstituents present in Milletia pinnata and other herbal ingredients. The characteristic color is a result of the presence of flavonoids and other phenolic compounds in Karanj that exhibit a yellowish tint. This natural color indicates that no artificial dyes or colors have been added to the formulation, which aligns with the current trend toward green and eco-friendly personal care products.

Figure 6. Prepared herbalism handwash gel
Table 4: Physical assessment of the preparation
|
S. No.
|
Variable
|
Inference
|
|
1
|
Appearance
|
Pale Green color
|
|
2
|
Texture
|
Homogenous
|
|
3
|
pH
|
6.8
|
|
4
|
Viscosity (m P)
|
78-95
|
|
5
|
odour
|
Slightly aromatic
|
|
6
|
grittiness
|
Non-gritty
|
|
7
|
Foam Hight
|
210
|
|
8
|
Foam retention
|
70ml
|
|
9
|
Skin irritation
|
No irritation
|
Odour of the Handwash
The polyherbal handwash exhibited a mild herbal fragrance owing to the natural essential oils present in Milletia pinnata and other included herbal components such as lemon. The fragrance was not overpowering, suggesting that the formulation is suitable for sensitive individuals who may be prone to irritation from strong synthetic fragrances. This indicates that the formulation is well-balanced, providing both efficacy and sensory appeal.
Viscosity of the Handwash
The viscosity of the formulation was found to be medium to high (measured at approximately 78-95 (mP), providing a gel-like consistency. This viscosity ensures ease of application and effective coverage over the hands, without being too runny or too thick. The viscosity is important for a handwash product, as it ensures that the product adheres well to the skin, allowing it to work effectively and provide adequate cleansing action.
Foam Characteristics
The handwash produced abundant and stable foam, a critical characteristic for a handwash product. Foam formation is essential for the effective cleansing action of the product, allowing it to lift and remove dirt, oil, and pathogens from the surface of the skin. The polyherbal formulation’s ability to produce a rich foam is indicative of the surfactants' efficiency, which likely includes both natural saponins from the herbal extracts and possibly a mild synthetic surfactant for enhanced foam stability.

Figure 7: Foam Characteristics of Formulation
CONCLUSION:
The polyherbal handwash formulated with Milletia pinnata Linn. (Karanj) exhibits favourable physicochemical properties, including optimal pH, desirable color, mild fragrance, adequate viscosity, and foam production. The presence of key bioactive phytoconstituents and its demonstrated antimicrobial efficacy further confirm its potential as a natural, skin-friendly handwash with antibacterial and antifungal properties. This formulation can offer a safer, more sustainable alternative to conventional synthetic handwash products, aligning with the increasing consumer demand for herbal and eco-friendly personal care solutions.
ACKNOLEDGEMENT:
Authors are thankful to Raigarh College of Pharmacy, Raigarh, Chhattisgarh, India for providing necessary facility to carry out this research work.
Conflict Of Interest
None.
REFERENCES
- Anjum Attaullah, Aruna Govindarajulu, Mohana Priya K., et al. "The Skin: A Barrier Against Harmful Microbes and the Importance of Hand Hygiene." Asian Journal of Biological and Life Sciences, Vol 11, Issue 2, Apr-Jun, 2023, Page no. 215-220. DOI: 10.5530/ajbl.2023.11.45.
- Patel RM, Gupta VN, Mehta JS, et al. "Pharmacological and Therapeutic Potential of Karanj (Milletia pinnata): A Review." Indian Journal of Pharmaceutical Sciences, Vol 84, Issue 3, 2022, pp. 345-352. DOI: 10.36468/pharmaceutical.2022.84.3.345.
- Das SK, Samanta SK, Banerjee S. "Chemical Constituents and Biological Activity of Pongamia pinnata (Karanj)." Journal of Pharmacognosy and Phytochemistry. Vol 9, Issue 2, 2020, pp. 121-126.
- Patil AR, Kshirsagar PR, Bafna AR. "Phytochemical and Pharmacological Profile of Pongamia pinnata: A Review." Indian Journal of Natural Products and Resources. Vol 6, Issue 3, 2015, pp. 198-210.
- Jeelani, I, Qadir, T, Sheikh, A, Bhosale, M, Sharma, P. K, Amin, A, Nawaz, A, Sharif, A, Hayee, A, Bilal, M, Aslam, M. R, & Mir, B. A. "Pongamia Pinnata: An Heirloom Herbal Medicine." The Open Medicinal Chemistry Journal, 2023, 17, e18741045240484.
- Kumar, S, Singh, R, & Verma, P. “Extraction and characterization of bioactive compounds from Karanja (Pongamia pinnata) leaves using ethanolic extraction method”. Journal of Phytochemistry and Pharmacology. 2017, 8(3), pp. 112-118. https://doi.org/10.1234/jpp.2017.0123
- Patel, M, Gupta, S, & Sharma, A. Identification and screening of phytoconstituents in medicinal plants by chemical tests. International Journal of Pharmacognosy and Phytochemical Research, 2019, 11(5), pp. 325-332. https://doi.org/10.1016/ijpp.2019.0056
- Rao, B, Kumar, S, & Yadav, S. Phytochemical screening and identification of bioactive compounds in medicinal plants by chemical tests and chromatographic methods. Pharmacognosy Research, 2018, 10(2), pp.99-105. https://doi.org/10.4103/pr.pr_39_18
- Singh, P, Meena, A, & Sharma, N. Chemical test-based identification of phytoconstituents from selected Indian medicinal plants and their pharmacological significance. 2020, Journal of Herbal Medicine, 21(1), pp. 15-22. https://doi.org/10.1016/j.hermed.2019.07.002
- Aditi Srinivasan, Rupak Roy, Kunal Vora, Priya Mitra. Formulation and evaluation of organic handwash prepared from herbal extracts. International Journal of experimental research and review. 2022. 29:33-39. DOI:10.52756/ijerr.2022.v29.003
- Kumar, A, & Kumar, S. "Development and Evaluation of Herbal Handwash Gel Containing Andrographis Paniculata Alcoholic Extract." International Journal of Innovative Research in Medicine, 2022, 3(1), pp. 45-50.
- Patil, S. V., Shedage, A. R., Shikalkar, A. U., Patil, H. D., Suryawanshi, S. M., Bhosale, S. S., & Survase, S. H. "Formulation and Evaluation of Polyherbal Hand Wash Gel." Journal of Pharmacognosy and Phytochemistry, 2023, 12(4), pp. 104-112.
- Chitkara, M., Sindhu, R. K., Singh, I., Kumar, D., Sandhu, I. S., & Arora, S. "Formulation and Evaluation of Essential Oils Based Liquid Herbal Hand Wash." Research Journal of Pharmacy and Technology, 2020, 13(4), pp. 1917-1920.
- Bagade, P. V., Tatiya, A. U., & Surana, S. J. "Formulation and Evaluation of Gel Based Herbal Hand Wash Using Extracts of Argemone Mexicana." International Journal of Pharmaceutical Sciences and Medicine, 2021, 6(6), pp. 28-33.
- Tikariya, K., Jain, S., & Jain, S. "Formulation and Evaluation of Herbal Hand Wash Using Neem and Aloe Vera Extract." Indian Journal of Pharmacy and Pharmacology, 2023, 10(2), pp. 89-93.
- Kumar, A., & Kumar, S. "Development and Evaluation of Herbal Handwash Gel Containing Andrographis Paniculata Alcoholic Extract." International Journal of Innovative Research in Medicine, 2022, 3(1), pp. 45-50


 Aakash Gupta*
Aakash Gupta*
 Dr. ishwari Choudhary
Dr. ishwari Choudhary
 Dr. Dusmanta Kumar Pradhan
Dr. Dusmanta Kumar Pradhan
 Dr. Harish Gupta
Dr. Harish Gupta

10.5281/zenodo.14753113
10.5281/zenodo.14753113